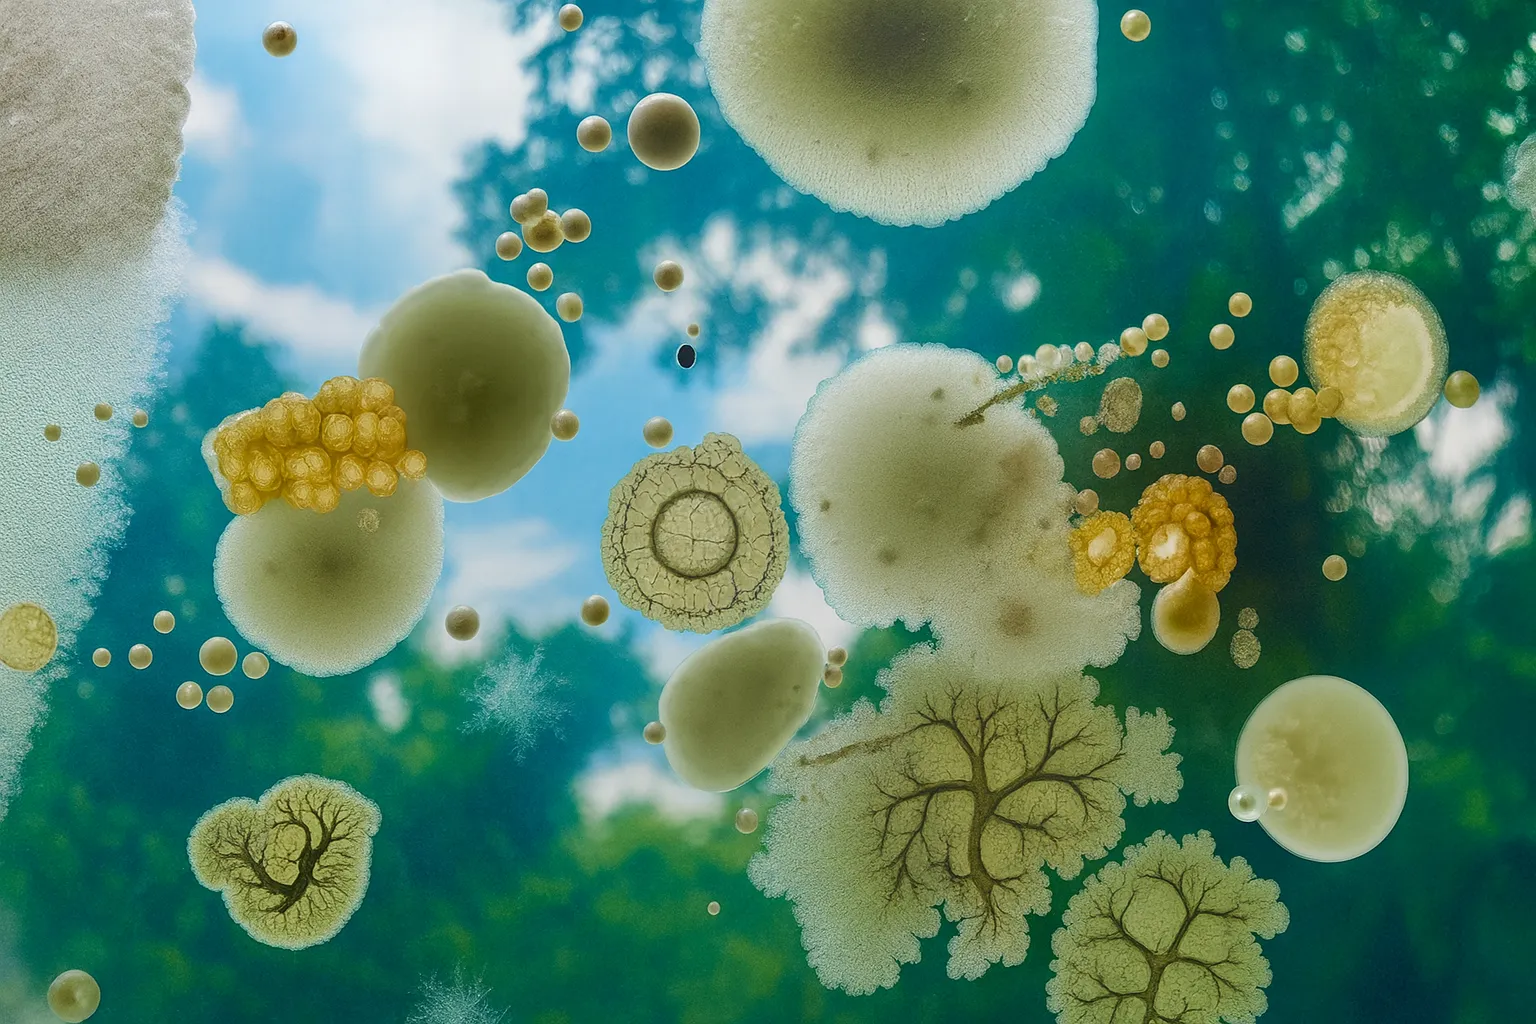

Al in 2015 spraken we Suzanne Lee, modepionier en grondlegger van biodesign, die als eerste kleding liet groeien uit micro-organismen. Vijf jaar later, in 2020, vertelde ze ons hoe ze met Biofabricate werkte aan een toekomst waarin duurzame, levende materialen de norm zouden worden.
Wat toen nog visionair klonk, krijgt vandaag steeds meer vorm. Biofabricatie ontwikkelt zich razendsnel tot een beweging die mode, design en materiaalinnovatie blijvend verandert. Een belangrijke motor achter die ontwikkeling is Biofabricate, wereldwijd hét platform voor biomaterialen. Hier komen wetenschap, design en natuur samen om onze maakcultuur radicaal te herdenken. En vooral ook doen.

Sinds de oprichting in 2014 verbindt Biofabricate baanbrekende start-ups met grote merken en vertaalt het grensverleggende wetenschap naar tastbare toepassingen. Van mode en interieur tot beauty en biotech: de organisatie versnelt de overgang van uitputtende grondstoffen naar materialen die groeien uit schimmels, microben en algen. Daarmee biedt Biofabricate niet alleen oplossingen, maar ook een inspirerende, levende toekomstvisie.

Wij volgen dit onderwerp kortom al jaren. Op 24 oktober zetten we de volgende stap. Tijdens het Next Nature Bio Conference verwelkomen we niemand minder dan Dr. Amy Congdon van Biofabricate, die de nieuwste inzichten deelt over deze veelbelovende discipline. Hét moment om - live - mee te maken waar dit belangrijke domein ons naartoe brengt.

Comments (0)
Share your thoughts and join the technology debate!
No comments yet
Be the first to share your thoughts!